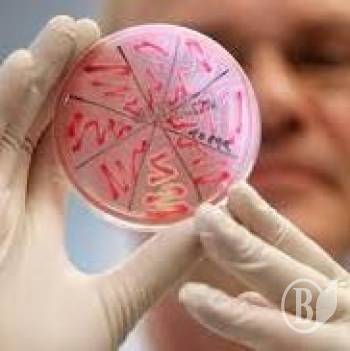
()

Зараза сидить на руках у медперсоналу (відео)
70% випадків хвороб, які пацієнти чіпляють у лікарнях, стаються через брудні руки медперсоналу.
Причинами решти 30% так званих "шпитальних" інфекцій є загальна нестерильність чи ще страшніше - неуважність медиків.
Першою у списку лікарняних небезпек стоїть синьогнійна паличка. Поруч стафілокок, далі йде гепатит В і С.
Статистика Всесвітньої організації охорони здоров'я не оптимістична: інфекції з медзакладів виносить щочетвертий пацієнт.
- Не всі навіть ці одноразові рукавички одягають. І не в усіх вони є, - нарікає директор центру моніторингу захворювань МОЗ Любов Некрасова.
Нерідко віруси та інфекції виносять з операційних і пологових залів - місць, де апріорі стерильним має бути все.
Статистика шпитальних недуг в Україні дуже приблизна. Наприклад, за 2012 рік виявили лише 500 післяопераційних ускладнень. Медики своєї провини просто не визнають.
Постанова Кабміну, яка діє з минулого року, не дозволяє санепідемстанції проводити перевірки частіше ніж раз на рік.
| Версія для друку Відправити по e-mail Обговорити на форумі |
| Переглядів : 8469 |






































Коментарі (2)
Проф. Преображенский | 2013-03-21 10:25
Oligert | 2013-03-21 00:50